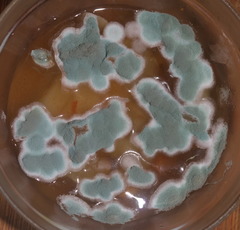
Trichocomaceae
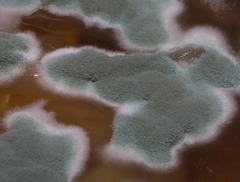
Trichocomaceae

Trichocomaceae: taxon details and analytics
- Domain
- Kingdom
- Fungi
- Phylum
- Ascomycota
- Class
- Eurotiomycetes
- Order
- Eurotiales
- Family
- Trichocomaceae
- Genus
- Species
- Scientific Name
- Trichocomaceae
Summary description from Wikipedia:
Trichocomaceae
The Trichocomaceae are a family of fungi in the order Eurotiales. Taxa are saprobes with aggressive colonization strategies, adaptable to extreme environmental conditions. Family members are cosmopolitan in distribution, ubiquitous in soil, and common associates of decaying plant and food material.
...Trichocomaceae in languages:
- Czech
- plísňovkovité
- Japanese
- マユハキタケ科
Images from inaturalist.org observations:
We recommend you sign up for this excellent, free service.